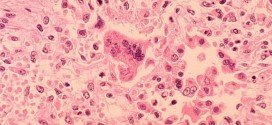
Sixth measles case confirmed in Niagara, official says

Newly-single Nicole Scherzinger has decided to change up her look by dyeing her hair blonde. Taking to Instagram, the 36-year-old shared a snap of her gorgeous new ‘do, styled in perfect curls.
Read More »World
Philip Pickett : Music Teacher Jailed for Sex Attacks On Girls
Philip Pickett, A teacher from a prestigious music school has been jailed for 11 years for “exceptionally serious” sex attacks on two schoolgirls and a young woman in sound-proof practice rooms, it can be reported.
Read More »Craig Finn lost leg after ‘pals set him on fire as he slept drunk on bathroom floor’
Craig Finn, A British man went into coma, lost leg after friends allegedly set him on fire when he passed out drunk. His mum Diane, revealed he and his three sisters feared Craig was close to death at one stage.
Read More »Ralitsa Ivanova : Bulgarian model accused of wrong-way DUI
Ralitsa Ivanova, A professional model living in St. Petersburg was arrested early Wednesday and charged with driving under the influence of alcohol, the Pasco County Sheriff’s Office said.
Read More »Bruce Jenner Jail Time Possible? (Video)
Could Bruce Jenner Face Jail Time Stemming from Fatal Malibu Car Crash? According to the Police Department, the entire accident was caught on tape by an MTA bus going the opposite direction.
Read More »Bride Marries Guest after Learning Groom is Epileptic (Details)
An Angry Indian Bride Marries A Guest After Her Groom Suffers A Seizure In The Middle Of Their Wedding! During one of the preliminary ceremonies of the Hindu wedding – the exchange of garlands – Jugal Kishore, 25, had an epileptic fit and fell to the floor at the wedding venue in the northern Indian town of Rampur, the Times …
Read More »Sixth measles case confirmed in Niagara, official says
Health officials in Niagara Region have confirmed a sixth cases of measles they say is linked to the other five. Medical Officer of Health Dr. Valerie Jaeger says the new case is a female under the age of 30 who was not vaccinated and a direct link to the other cases has been established.
Read More »Stolen Clown Joyland : Long-lost Kansas amusement park clown found in sex offender’s home
Stolen clown found? the long-missing mascot of Wichita’s Joyland amusement park, has been recovered
Read More »Selena Gomez Poses Topless in New Magazine Spread (Photo)
Selena Gomez poses topless for magazine, The 22-year-old former Disney star appeared on the front cover wearing high-waisted denim shorts, red hoop earrings and her hair in a long, black perm with a red bow.
Read More »New Zealand Fans Livid Over Ciara’s 10 Minute Concert
Ciara 10 minute concert performance outrages 1500 fans in New Zealand, According to News Corp, the artist, whose hits include Goodies, 1, 2 Step and Love Sex Magic, took the stage at ILAM Fields, Canterbury University just prior to 11pm, which is when a noise curfew comes into effect. She was allegedly slated to begin her performance at 9:30pm.
Read More »Duchess Kate Switches Her Hair Up to a Knotted Half-Up Hairstyle (Photo)
Duchess Kate Gets Knotted, Sets Another Hair Trend. Looking radiant, the striking brunette was wearing her hair in a half-up, half-down ‘do. Part of her hair had been tied up using a lock of her own strands for a polished finished while the ends of her long locks had been styled into bouncy curls.
Read More » Canada Journal – News of the World Articles and videos to bring you the biggest Canadian news stories from across the country every day
Canada Journal – News of the World Articles and videos to bring you the biggest Canadian news stories from across the country every day